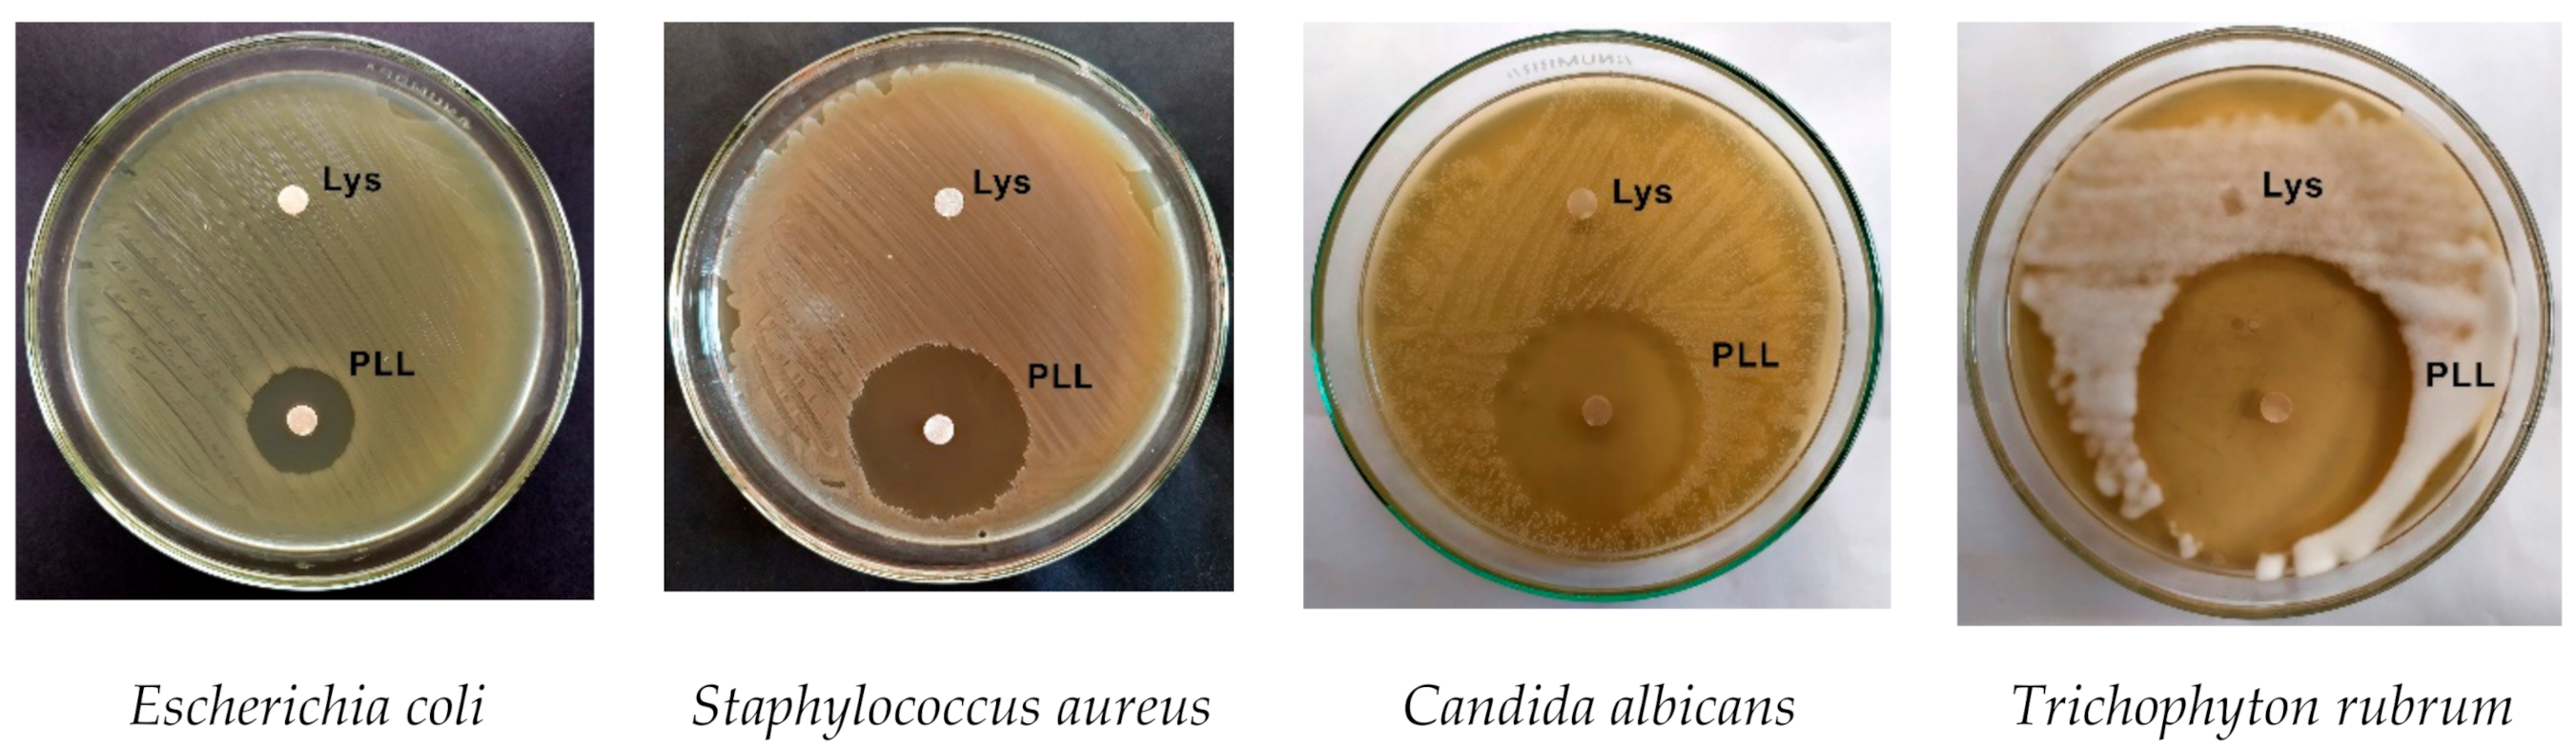

Antimicrobial Activity of L-Lysine and Poly-L-Lysine with Pulsed Electric Fields
Abstract
1. Introduction
2. Materials and Methods
2.1. Preparation of L-Lysine and Poly-L-Lysine
2.2. Preparation of Cells
2.3. Antimicrobial Activity of L-Lysine and Poly-L-Lysine
2.4. Pulsed Power Setup
2.5. Electroporation and Viability Assay
2.6. Statistical Analysis
3. Results
4. Discussion
5. Conclusions
Author Contributions
Funding
Institutional Review Board Statement
Informed Consent Statement
Data Availability Statement
Conflicts of Interest
References
- Grenni, P.; Ancona, V.; Barra Caracciolo, A. Ecological effects of antibiotics on natural ecosystems: A review. Microchem. J. 2018, 136, 25–39. [Google Scholar] [CrossRef]
- Koch, B.J.; Hungate, B.A.; Price, L.B. Food-animal production and the spread of antibiotic resistance: The role of ecology. Front. Ecol. Environ. 2017, 15, 309–318. [Google Scholar] [CrossRef]
- Willyard, C. Drug-resistant bacteria ranked. Nature 2017, 543, 15. [Google Scholar] [CrossRef]
- WHO. WHO Estimates of the Global Burden of Foodborne Diseases; World Health Organization: Geneva, Switzerland, 2015; pp. 1–255. [Google Scholar]
- Ferrer, M.; Méndez-García, C.; Rojo, D.; Barbas, C.; Moya, A. Antibiotic use and microbiome function. Biochem. Pharmacol. 2017, 134, 114–126. [Google Scholar] [CrossRef] [PubMed]
- Li, W.; Yao, Z.; Sun, L.; Hu, W.; Cao, J.; Lin, W.; Lin, X. Proteomics Analysis Reveals a Potential Antibiotic Cocktail Therapy Strategy for Aeromonas hydrophila Infection in Biofilm. J. Proteome Res. 2016, 15, 1810–1820. [Google Scholar] [CrossRef]
- Deak, T. Thermal treatment. In Food Safety Management: A Practical Guide for the Food Industry; Motarjemi, Y., Lelieveld, H., Eds.; Academic Press: Amsterdam, The Netherlands, 2014; pp. 423–442. [Google Scholar]
- Ling, B.; Tang, J.; Kong, F.; Mitcham, E.J.; Wang, S. Kinetics of Food Quality Changes During Thermal Processing: A Review. Food Bioprocess Technol. 2015, 8, 343–358. [Google Scholar] [CrossRef]
- Shevchenko, S.N.; Burkhardt, M.; Sheval, E.V.; Natashina, U.A.; Grosse, C.; Nikolaev, A.L.; Gopin, A.V.; Neugebauer, U.; Kudryavtsev, A.A.; Sivakov, V.; et al. Antimicrobial Effect of Biocompatible Silicon Nanoparticles Activated Using Therapeutic Ultrasound. Langmuir 2017, 33, 2603–2609. [Google Scholar] [CrossRef] [PubMed]
- Duarte, A.L.A.; do Rosário, D.K.A.; Oliveira, S.B.S.; de Souza, H.L.S.; de Carvalho, R.V.; Carneiro, J.C.S.; Silva, P.I.; Bernardes, P.C. Ultrasound improves antimicrobial effect of sodium dichloroisocyanurate to reduce Salmonella Typhimurium on purple cabbage. Int. J. Food Microbiol. 2018, 269, 12–18. [Google Scholar] [CrossRef]
- Wang, B.; Wang, M.; Mikhailovsky, A.; Wang, S.; Bazan, G.C. A Membrane-Intercalating Conjugated Oligoelectrolyte with High-Efficiency Photodynamic Antimicrobial Activity. Angew. Chemie Int. Ed. 2017, 56, 5031–5034. [Google Scholar] [CrossRef]
- Cieplik, F.; Buchalla, W.; Hellwig, E.; Al-Ahmad, A.; Hiller, K.A.; Maisch, T.; Karygianni, L. Antimicrobial photodynamic therapy as an adjunct for treatment of deep carious lesions–A systematic review. Photodiagn. Photodyn. Ther. 2017, 18, 54–62. [Google Scholar] [CrossRef]
- Brun, P.; Bernabè, G.; Marchiori, C.; Scarpa, M.; Zuin, M.; Cavazzana, R.; Zaniol, B.; Martines, E. Antibacterial efficacy and mechanisms of action of low power atmospheric pressure cold plasma: Membrane permeability, biofilm penetration and antimicrobial sensitization. J. Appl. Microbiol. 2018, 125, 398–408. [Google Scholar] [CrossRef]
- Misra, N.N.; Jo, C. Applications of cold plasma technology for microbiological safety in meat industry. Trends Food Sci. Technol. 2017, 64, 74–86. [Google Scholar] [CrossRef]
- Korem, M.; Goldberg, N.S.; Cahan, A.; Cohen, M.J.; Nissenbaum, I.; Moses, A.E. Clinically applicable irreversible electroporation for eradication of micro-organisms. Lett. Appl. Microbiol. 2018, 67, 15–21. [Google Scholar] [CrossRef]
- Novickij, V.; Stanevičienė, R.; Vepštaitė-Monstavičė, I.; Gruškienė, R.; Krivorotova, T.; Sereikaitė, J.; Novickij, J.; Servienė, E. Overcoming antimicrobial resistance in bacteria using bioactive magnetic nanoparticles and pulsed electromagnetic fields. Front. Microbiol. 2018, 9, 2678. [Google Scholar] [CrossRef]
- Tsong, T.Y.Y. Electroporation of cell membranes. Biophys. J. 1991, 60, 297–306. [Google Scholar] [CrossRef]
- Chen, C.; Smye, S.W.; Robinson, M.P.; Evans, J.A. Membrane electroporation theories: A review. Med. Biol. Eng. Comput. 2006, 44, 5–14. [Google Scholar] [CrossRef] [PubMed]
- Kotnik, T.; Kramar, P.; Pucihar, G.; Miklavčič, D.; Tarek, M. Cell membrane electroporation—Part 1: The phenomenon. IEEE Electr. Insul. Mag. 2012, 28, 14–23. [Google Scholar] [CrossRef]
- Silve, A.; Leray, I.; Leguèbe, M.; Poignard, C.; Mir, L.M. Cell membrane permeabilization by 12-ns electric pulses: Not a purely dielectric, but a charge-dependent phenomenon. Bioelectrochemistry 2015, 106, 369–378. [Google Scholar] [CrossRef]
- Rubinsky, B. Irreversible electroporation in medicine. Technol. Cancer Res. Treat. 2007, 6, 255–260. [Google Scholar] [CrossRef]
- Sack, M.; Sigler, J.; Frenzel, S.; Eing, C.; Arnold, J.; Michelberger, T.; Frey, W.; Attmann, F.; Stukenbrock, L.; Müller, G. Research on industrial-scale electroporation devices fostering the extraction of substances from biological tissue. Food Eng. Rev. 2010, 2, 147–156. [Google Scholar] [CrossRef]
- Mali, B.; Jarm, T.; Snoj, M.; Sersa, G.; Miklavcic, D. Antitumor effectiveness of electrochemotherapy: A systematic review and meta-analysis. Eur. J. Surg. Oncol. 2013, 39, 4–16. [Google Scholar] [CrossRef]
- Of, J.; Biology, M.; Mahni, S.; Universit, K.; Universit, E.V. Electroporation in Food Processing and Biorefinery Electroporation in Food Processing and Biorefinery. J. Membr. Biol. 2014, 47, 1279–1304. [Google Scholar]
- Novickij, V.; Zinkevičienė, A.; Perminaitė, E.; Čėsna, R.; Lastauskienė, E.; Paškevičius, A.; Švedienė, J.; Markovskaja, S.; Novickij, J.; Girkontaitė, I. Non-invasive nanosecond electroporation for biocontrol of surface infections: An in vivo study. Sci. Rep. 2018, 8, 14516. [Google Scholar] [CrossRef] [PubMed]
- Khan, S.I.; Blumrosen, G.; Vecchio, D.; Golberg, A.; McCormack, M.C.; Yarmush, M.L.; Hamblin, M.R.; Austen, W.G., Jr. Eradication of multidrug-resistant Pseudomonas biofilm with pulsed electric fields. Biotechnol. Bioeng. 2016, 113, 643–650. [Google Scholar] [CrossRef]
- Golberg, A.; Broelsch, G.F.; Vecchio, D.; Khan, S.; Hamblin, M.R.; Austen, W.G., Jr.; Sheridan, R.L.; Yarmush, M.L. Pulsed electric fields for burn wound disinfection in a murine model. Pulsed electric fields for burn wound disinfection in a murine model. J. Burn. Care Res. 2015, 36, 7–13. [Google Scholar] [CrossRef] [PubMed]
- Miklavčič, D.; Serša, G.; Brecelj, E.; Gehl, J.; Soden, D.; Bianchi, G.; Ruggieri, P.; Rossi, C.R.; Campana, L.G.; Jarm, T. Electrochemotherapy: Technological advancements for efficient electroporation-based treatment of internal tumors. Med. Biol. Eng. Comput. 2012, 50, 1213–1225. [Google Scholar] [CrossRef]
- Novickij, V.; Zinkevičienė, A.; Stanevičienė, R.; Gruškienė, R.; Servienė, E.; Vepštaitė-Monstavičė, I.; Krivorotova, T.; Lastauskienė, E.; Sereikaitė, J.; Girkontaitė, I.; et al. Inactivation of Escherichia coli Using Nanosecond Electric Fields and Nisin Nanoparticles: A Kinetics Study. Front. Microbiol. 2018, 9, 3006. [Google Scholar] [CrossRef] [PubMed]
- Martín-Belloso, O.; Sobrino-López, A. Combination of Pulsed Electric Fields with Other Preservation Techniques. Food Bioprocess Technol. 2011, 4, 954–968. [Google Scholar] [CrossRef]
- Smith, K.; Mittal, G.S.; Griffiths, M.W. Pasteurization of milk using pulsed electrical field and antimicrobials. J. Food Sci. 2002, 67, 2304–2308. [Google Scholar] [CrossRef]
- Ravensdale, J.; Wong, Z.; O’Brien, F.; Gregg, K. Efficacy of antibacterial peptides against peptide-resistant MRSA is restored by permeabilization of bacteria membranes. Front. Microbiol. 2016, 7, 1745. [Google Scholar] [CrossRef] [PubMed]
- Novickij, V.; Švedienė, J.; Paškevičius, A.; Markovskaja, S.; Lastauskienė, E.; Zinkevičienė, A.; Girkontaitė, I.; Novickij, J. Induction of Different Sensitization Patterns of MRSA to Antibiotics Using Electroporation. Molecules 2018, 23, 1799. [Google Scholar] [CrossRef] [PubMed]
- Vadlamani, A.; Detwiler, D.A.; Dhanabal, A.; Garner, A.L. Synergistic bacterial inactivation by combining antibiotics with nanosecond electric pulses. Appl. Microbiol. Biotechnol. 2018, 102, 7589–7596. [Google Scholar] [CrossRef]
- Zardini, H.Z.; Amiri, A.; Shanbedi, M.; Maghrebi, M.; Baniadam, M. Enhanced antibacterial activity of amino acids-functionalized multi walled carbon nanotubes by a simple method. Colloids Surf. B Biointerfaces 2012, 92, 196–202. [Google Scholar] [CrossRef] [PubMed]
- Amiri, A.; Zardini, H.Z.; Shanbedi, M.; Maghrebi, M.; Baniadam, M.; Tolueinia, B. Efficient method for functionalization of carbon nanotubes by lysine and improved antimicrobial activity and water-dispersion. Mater. Lett. 2012, 72, 153–156. [Google Scholar] [CrossRef]
- Dubois, A.V.; Midoux, P.; Gras, D.; Si-Tahar, M.; Bréa, D.; Attucci, S.; Khelloufi, M.K.; Ramphal, R.; Diot, P.; Gauthier, F.; et al. Poly-L-lysine compacts DNA, kills bacteria, and improves protease inhibition in cystic fibrosis sputum. Am. J. Respir. Crit. Care Med. 2013, 188, 703–709. [Google Scholar] [CrossRef]
- Isaksson, K.; Åkerberg, D.; Posaric-Bauden, M.; Andersson, R.; Tingstedt, B. In vivo toxicity and biodistribution of intraperitoneal and intravenous poly-l-lysine and poly-l-lysine/poly-l-glutamate in rats. J. Mater. Sci. Mater. Med. 2014, 25, 1293–1299. [Google Scholar] [CrossRef]
- Pucihar, G.; Krmelj, J.; Reberšek, M.; Napotnik, T.B.; Miklavčič, D. Equivalent pulse parameters for electroporation. IEEE Trans. Biomed. Eng. 2011, 58, 3279–3288. [Google Scholar] [CrossRef] [PubMed]
- Novickij, V.; Ruzgys, P.; Grainys, A.; Šatkauskas, S. High frequency electroporation efficiency is under control of membrane capacitive charging and voltage potential relaxation. Bioelectrochemistry 2018, 119, 92–97. [Google Scholar] [CrossRef]
- Denzi, A.; Merla, C.; Palego, C.; Paffi, A.; Ning, Y.; Multari, C.R.; Cheng, X.; Apollonio, F.; Hwang, J.C.; Liberti, M. Assessment of cytoplasm conductivity by nanosecond pulsed electric fields. IEEE Trans. Biomed. Eng. 2015, 62, 1595–1603. [Google Scholar] [CrossRef]
- European Committee for Antimicrobial Susceptibility Testing (EUCAST) of the European Society of Clinical Microbiology and Infectious Diseases (ESCMID). Determination of minimum inhibitory concentrations (MICs) of antibacterial agents by broth dilution. Clin. Microbiol. Infect. 2003, 9, ix–xv. [Google Scholar] [CrossRef]
- Novickij, V.; Grainys, A.; Butkus, P.; Tolvaišienė, S.; Švedienė, J.; Paškevičius, A.; Novickij, J. High-frequency submicrosecond electroporator. Biotechnol. Biotechnol. Equip. 2016, 30, 607–613. [Google Scholar] [CrossRef]
- Vadlamani, R.A.; Dhanabal, A.; Detwiler, D.A.; Pal, R.; McCarthy, J.; Seleem, M.N.; Garner, A.L. Nanosecond electric pulses rapidly enhance the inactivation of Gram-negative bacteria using Gram-positive antibiotics. Appl. Microbiol. Biotechnol. 2020, 104, 2217–2227. [Google Scholar] [CrossRef]
- Wang, T.; Chen, H.; Yu, C.; Xie, X. Rapid determination of the electroporation threshold for bacteria inactivation using a lab-on-a-chip platform. Environ. Int. 2019, 132, 105040. [Google Scholar] [CrossRef]
- Batista Napotnik, T.; Reberšek, M.; Vernier, P.T.; Mali, B.; Miklavčič, D. Effects of high voltage nanosecond electric pulses on eucaryotic cells (in vitro): A systematic review. Bioelectrochemistry 2016, 10, 1–12. [Google Scholar] [CrossRef]
- Kotnik, T.; Rems, L.; Tarek, M.; Miklavčič, D. Membrane Electroporation and Electropermeabilization: Mechanisms and Models. Annu. Rev. Biophys. 2019, 48, 63–91. [Google Scholar] [CrossRef] [PubMed]
- Ruzgys, P.; Jakutavičiūtė, M.; Šatkauskienė, I.; Čepurnienė, K.; Šatkauskas, S. Effect of electroporation medium conductivity on exogenous molecule transfer to cells in vitro. Sci. Rep. 2019, 9, 1436. [Google Scholar] [CrossRef] [PubMed]
- Shima, S.; Matsuoka, H.; Iwamoto, T.; Sakai, H. Antimicrobial action of E-poly-L-lysine. J. Antibiot. 1984, 37, 1449–1455. [Google Scholar] [CrossRef]
- Hyldgaard, M.; Mygind, T.; Vad, B.S.; Stenvang, M.; Otzen, D.E.; Meyer, R.L. The antimicrobial mechanism of action of epsilon-poly-L-lysine. Appl. Environ. Microbiol. 2014, 80, 7758–7770. [Google Scholar] [CrossRef]
- Tan, Z.; Shi, Y.; Xing, B.; Hou, Y.; Cui, J.; Jia, S. The antimicrobial effects and mechanism of ε-poly-lysine against Staphylococcus aureus. Bioresour. Bioprocess. 2019, 6, 11. [Google Scholar] [CrossRef]
- Nowosad, K.; Sujka, M.; Pankiewicz, U.; Kowalski, R. The application of PEF technology in food processing and human nutrition. J. Food Sci. Technol. 2021, 58, 397–411. [Google Scholar] [CrossRef] [PubMed]
- Tao, X.; Chen, J.; Li, L.; Zhao, L.; Zhang, M.; Sun, A. Influence of Pulsed Electric Field on Escherichia coli and Saccharomyces cerevisiae. Int. J. Food Prop. 2015, 18, 1416–1427. [Google Scholar] [CrossRef]
- Damar, S.; Bozogğlu, F.; Hızal, M.; Bayındırlı, A. Inactivation and injury of Escherichia coli O157:H7 and Staphylococcus aureus by pulsed electric fields. World J. Microbiol. Biotechnol. 2002, 18, 1–6. [Google Scholar] [CrossRef]

| Microorganisms | Lys | PLL |
|---|---|---|
| MIC | ||
| E. coli | 500 mg/ml | 250 mg/ml |
| S. aureus | 125 mg/ml | 2.4 ng/ml |
| C. albicans | NI * | 1.5 ng/ml |
| T. rubrum | NI | 0.3 ng/ml |
Publisher’s Note: MDPI stays neutral with regard to jurisdictional claims in published maps and institutional affiliations. |
© 2021 by the authors. Licensee MDPI, Basel, Switzerland. This article is an open access article distributed under the terms and conditions of the Creative Commons Attribution (CC BY) license (http://creativecommons.org/licenses/by/4.0/).
Share and Cite
Švedienė, J.; Novickij, V.; Žalnėravičius, R.; Raudonienė, V.; Markovskaja, S.; Novickij, J.; Paškevičius, A. Antimicrobial Activity of L-Lysine and Poly-L-Lysine with Pulsed Electric Fields. Appl. Sci. 2021, 11, 2708. https://doi.org/10.3390/app11062708
Švedienė J, Novickij V, Žalnėravičius R, Raudonienė V, Markovskaja S, Novickij J, Paškevičius A. Antimicrobial Activity of L-Lysine and Poly-L-Lysine with Pulsed Electric Fields. Applied Sciences. 2021; 11(6):2708. https://doi.org/10.3390/app11062708
Chicago/Turabian StyleŠvedienė, Jurgita, Vitalij Novickij, Rokas Žalnėravičius, Vita Raudonienė, Svetlana Markovskaja, Jurij Novickij, and Algimantas Paškevičius. 2021. "Antimicrobial Activity of L-Lysine and Poly-L-Lysine with Pulsed Electric Fields" Applied Sciences 11, no. 6: 2708. https://doi.org/10.3390/app11062708
APA StyleŠvedienė, J., Novickij, V., Žalnėravičius, R., Raudonienė, V., Markovskaja, S., Novickij, J., & Paškevičius, A. (2021). Antimicrobial Activity of L-Lysine and Poly-L-Lysine with Pulsed Electric Fields. Applied Sciences, 11(6), 2708. https://doi.org/10.3390/app11062708

